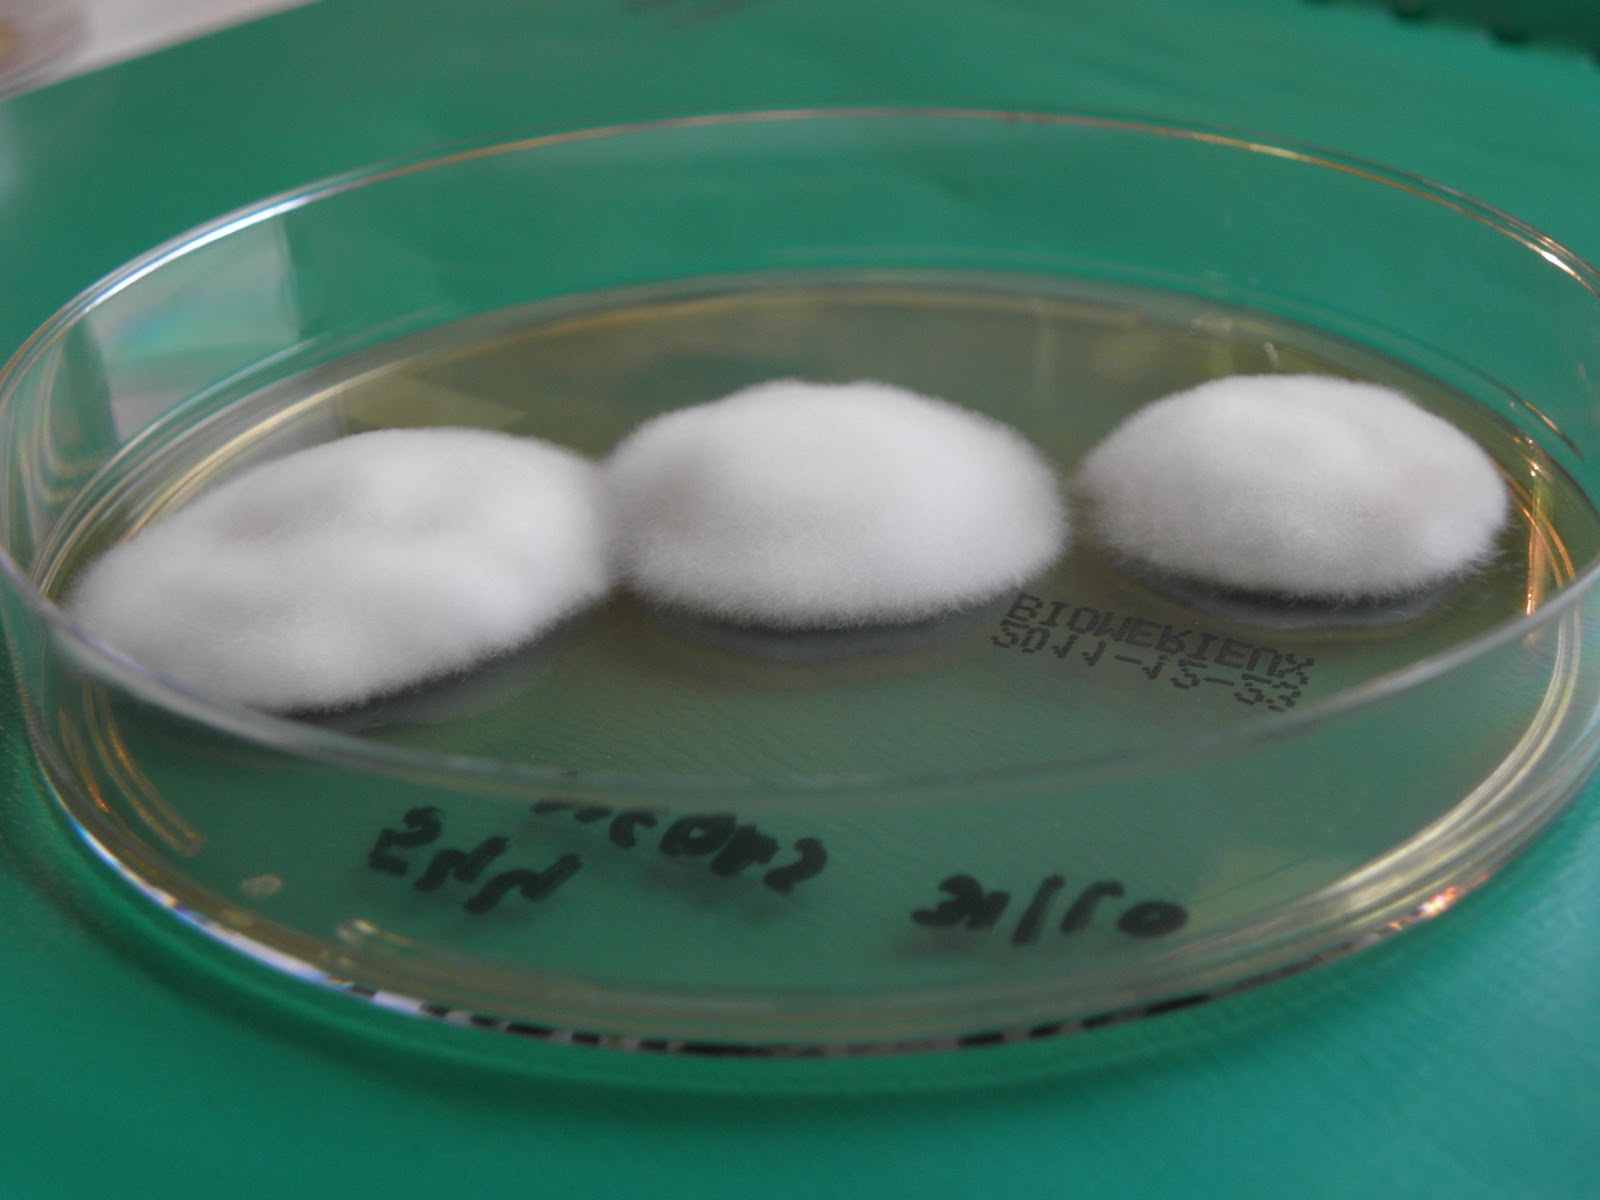
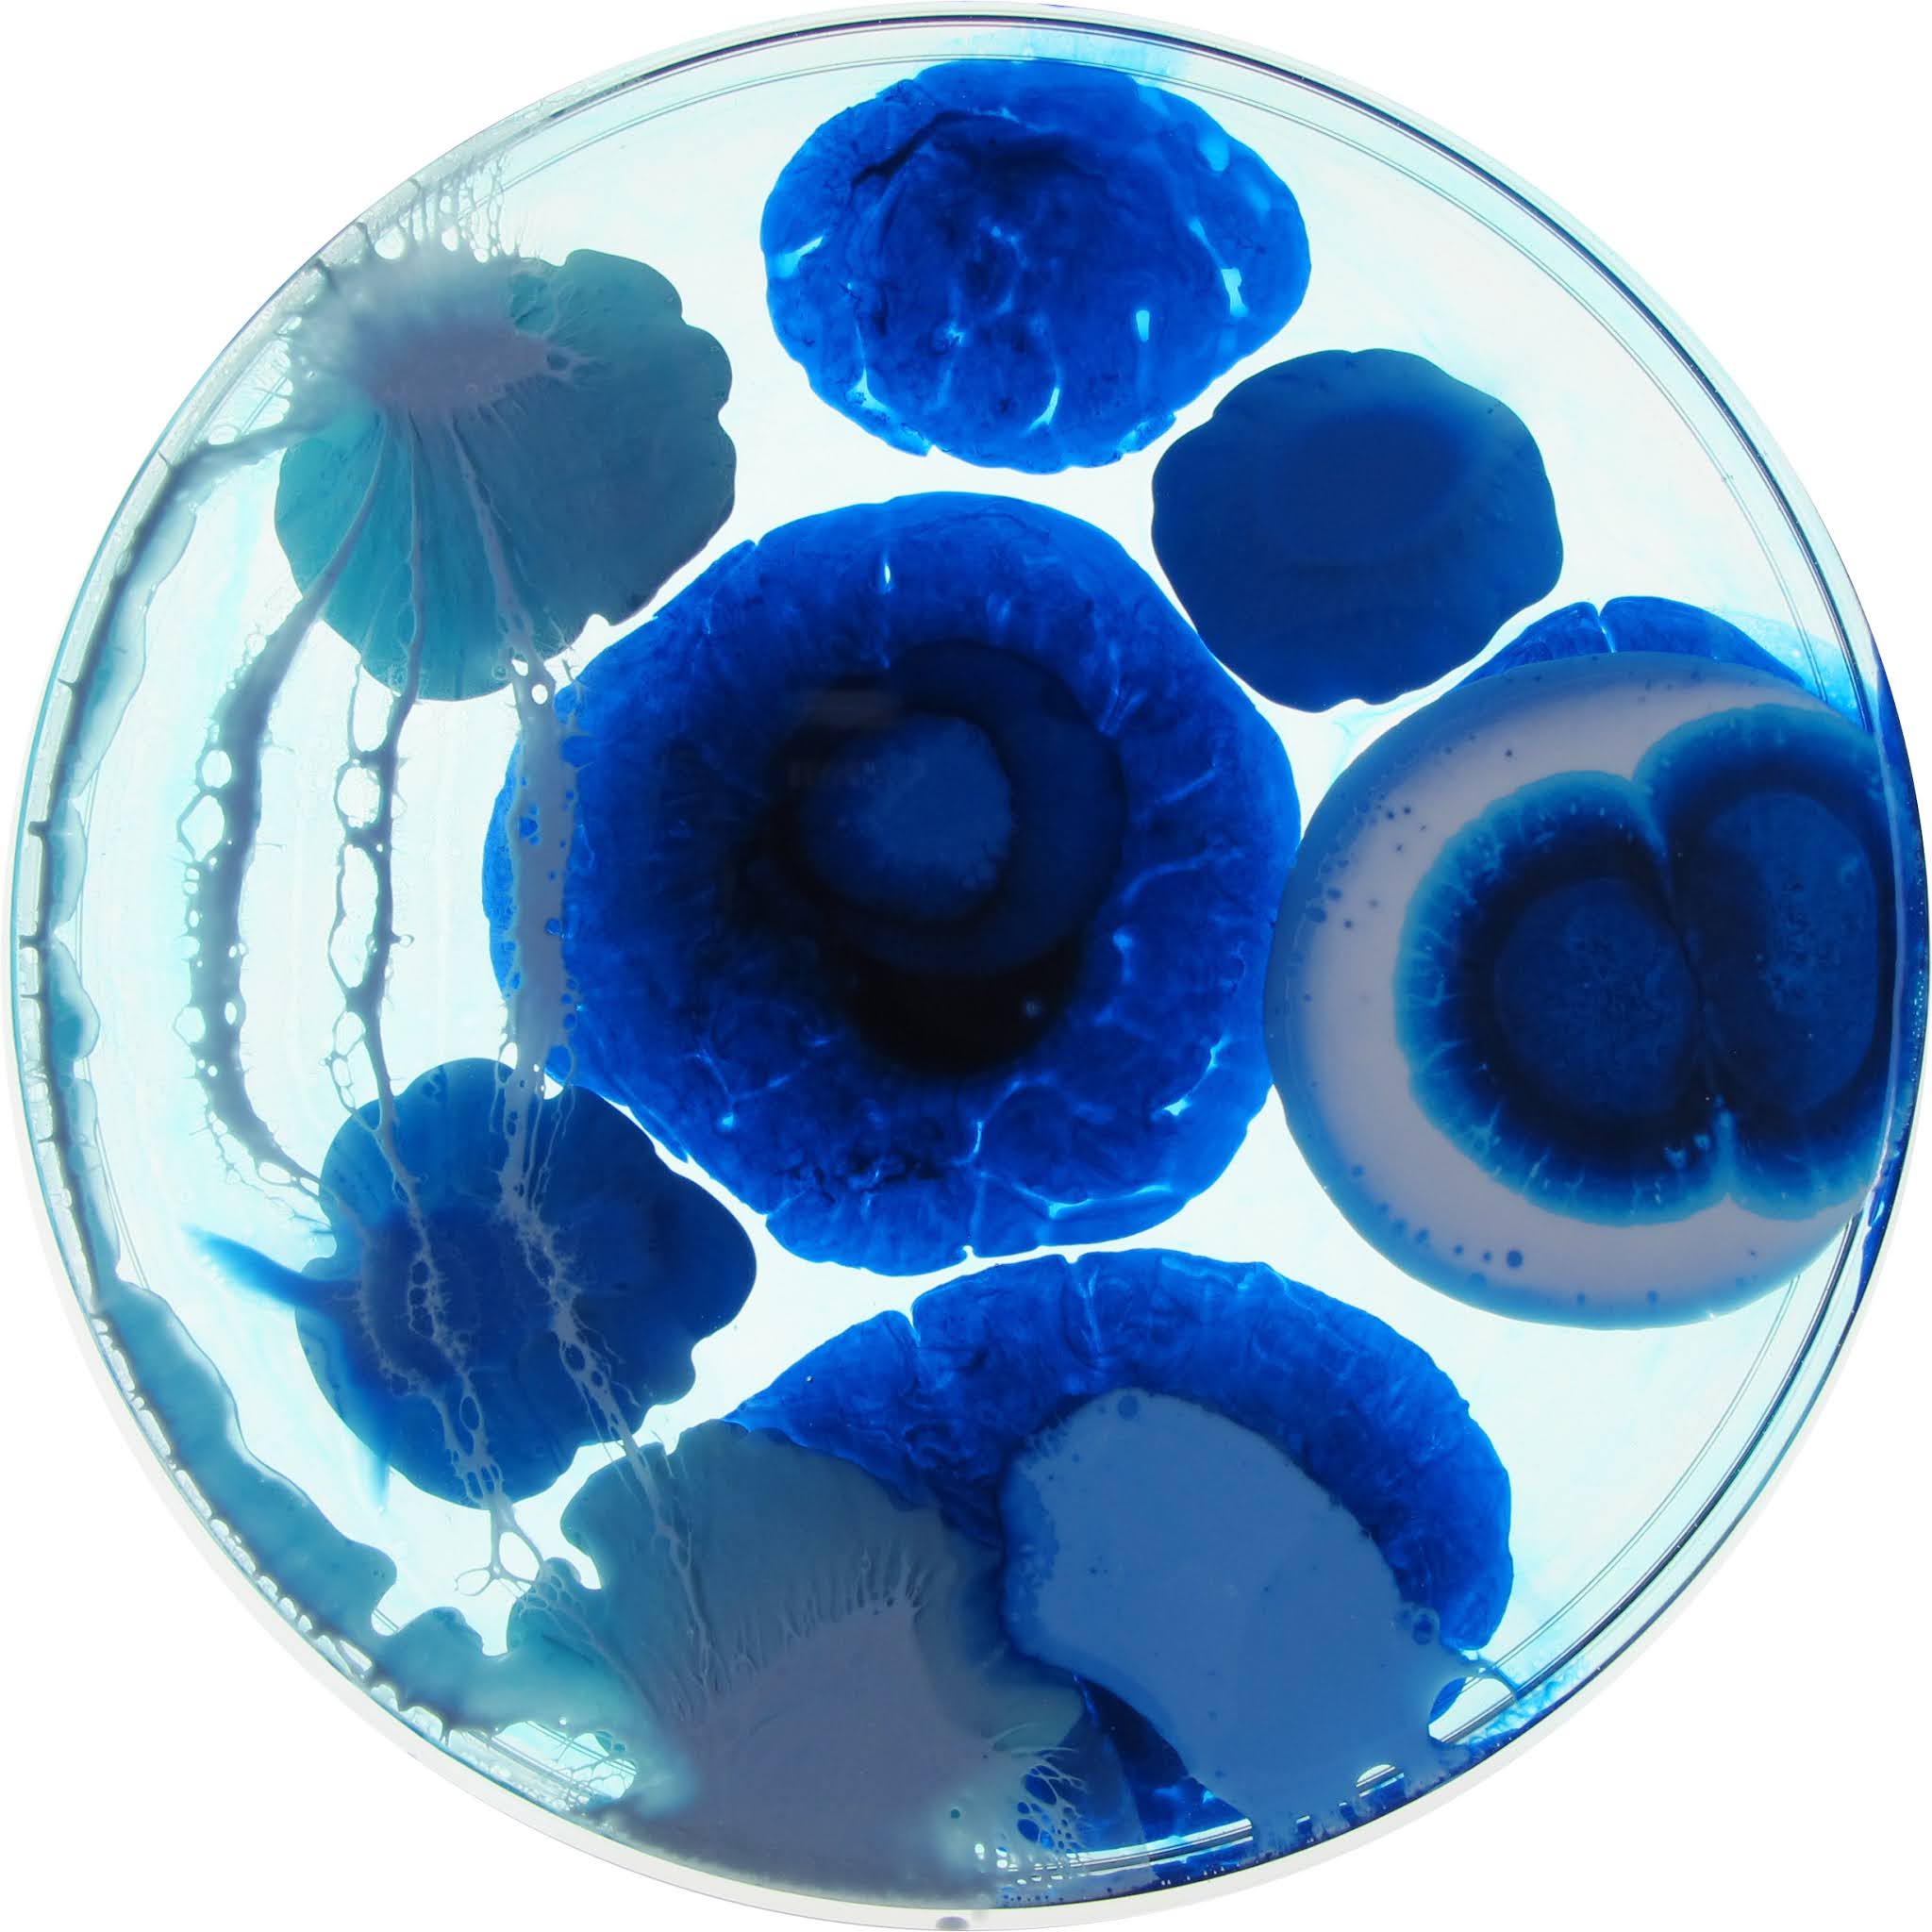

Trichophyton rubrum: формы и виды грибов

.jpg)

Раздел: Природная галерея